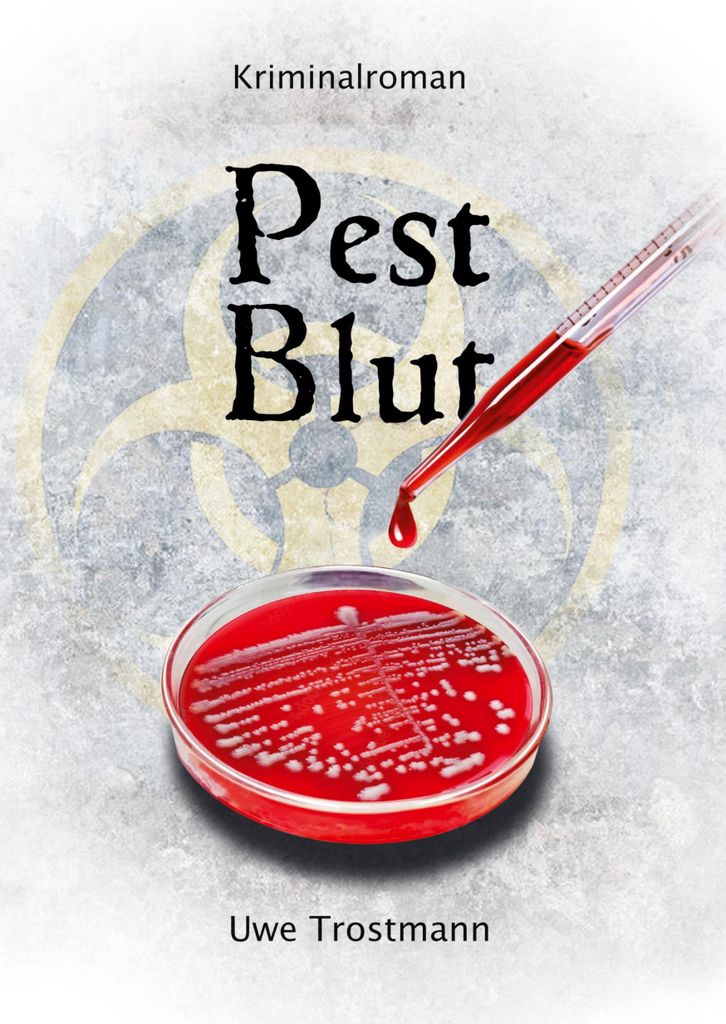
Pest Blut

DER SEEADLER Ein Portrait des größten Greifvogels Mitteleuropas (Wandkalender 2026 DIN A4 quer), CALVENDO Monatskalender
€21.99
inkl. MwSt. zzgl. Versand
Versand: €0.00

Ersatz TV Fernbedienung für Samsung UA40F5000AM Fernseher
€10.76
inkl. MwSt. zzgl. Versand
Versand: €3.46

V&B Spüle Linara 45 m Abl.garn, Exzenter, ivory CeramicPlus ; Villeroy & Boch
€796.99
inkl. MwSt. zzgl. Versand
Versand: €0.00

Disney Magical Movers, Rapunzel
€12.05
inkl. MwSt. zzgl. Versand
Versand: €6.50

Bio Ionic GoldPro Speed Dryer 2000 W
€153.90
inkl. MwSt. zzgl. Versand
Versand: €0.00

Achenberg Herren Trachtenhose Lederhose kurzhose mit Gürtel Ziegenvelour Stickerei, Größe:50/M
€329.00
inkl. MwSt. zzgl. Versand
Versand: €0.00

hansepuzzle 64853 - Wüste Puzzle, 1000 Teile, Natur, 60,0 x 46,0cm mit hochwertiger Aufbewahrung, Kartonbox und wiederverschließbarem Beutel
€25.95
inkl. MwSt. zzgl. Versand
Versand: €3.75

MuchoWow Koffer Handgepäck Trolley Rollkoffer Kleine Reisekoffer mit 4 Rollen - Vogel - Kohlmeise - Winter - Schnee - Zweige - Cabin Size < 55x4...
€99.99
inkl. MwSt. zzgl. Versand
Versand: €0.00

Ohrringen Ohrstecker Amen Silber Kollektion Titanic - frau
€76.73
inkl. MwSt. zzgl. Versand
Versand: €0.00

vidaXL Bettgestell Schwarz 90x190 cm Kunstleder
€67.99
inkl. MwSt. zzgl. Versand
Versand: €0.00

Schonbezüge Sitzbezüge für Subaru Outback 4 Bj 2009-14 in Schwarz PS803
€129.00
inkl. MwSt. zzgl. Versand
Versand: €0.00

Einschlaf Hörbuch für Erwachsene - Einschlaf Hörbuch für Erwachsene, Audio, 4066339396326
€4.99
inkl. MwSt. zzgl. Versand
Versand: €0.00

Herren Grafik T-Shirt Surf-Team Das Leben am Strand Reiten Sie die Wellen seit 1983 – Surf Team Beach Life Ride the Waves Since 1983 – Geschenk...
€18.95
inkl. MwSt. zzgl. Versand
Versand: €4.95

Poster mit Rahmen Kupfer "Kula Lumpur Flag" artboxONE - Städte,Reise,Reise / Asien,Reise / Länder,Städte / Weitere
€54.99
inkl. MwSt. zzgl. Versand
Versand: €4.99

MARKENfarbbänder MF 13 Harz-Ultra-Farbband
€8.69
inkl. MwSt. zzgl. Versand
Versand: €6.72

FAG 840 0881 10 Spurstangenkopf OE 7701054583 kompatibel mit Clio, Scenic, Megane
€19.00
inkl. MwSt. zzgl. Versand
Versand: €10.00

LASCANA T-Shirt-BH weiß Gr. 80C. Mit Bügel
€33.00
inkl. MwSt. zzgl. Versand
Versand: €4.95

Tortenträume - Traumtorten (Tischkalender 2026 DIN A5 quer), CALVENDO Monatskalender
€20.99
inkl. MwSt. zzgl. Versand
Versand: €0.00
HÜPPE Solva teilgerahmt 4-Eck Schwingtür 80 x 200 cm, Glas ohne Anti-Plaque, Rechtsbefestigung, Duschkabinen, silber hochglanz
€1,880.57
inkl. MwSt. zzgl. Versand
Versand: €59.95

Cadre photo H300 Rose 50 x 70 cm
€43.80
inkl. MwSt. zzgl. Versand

DECO WALLS Fototapete Kinderzimmer Pferd - Außergewöhnliche Haltbarkeit XXL 148x220 cm
€46.76
inkl. MwSt. zzgl. Versand
Versand: €0.00

Spreadshirt Bibi Blocksberg Film Das Große Hexentreffen Logo Uni Hoodie, XXL, Lavendel
€36.99
inkl. MwSt. zzgl. Versand
Versand: €3.99

Doppelter Vakuum-Kaffeebecher aus Edelstahl, pulverbeschichteter Reisebecher für Zuhause, Büro, Reisen, Party
€19.02
inkl. MwSt. zzgl. Versand
Versand: €0.00

Siku Traktor Claas Xerion mit Fasswagen; 1827
€16.70
inkl. MwSt. zzgl. Versand
Versand: €4.99

Erdbohrer mit Griff 180 mm Verlängerungsrohr 5 m
€105.77
inkl. MwSt. zzgl. Versand
Versand: €0.00

Mr. & Mrs. Panda Mikrofaserdecke Stinktier Handstand - Weiß - Geschenk, Bettdecke, Decke, Flauschige Kuscheldecke, Verpielt, Kunstfelldecke, Spiel...
€54.99
inkl. MwSt. zzgl. Versand
Versand: €4.90

ABAKUHAUS Cacti Kissenbezug, Botanical Cactus und Herzen, mit Reißverschluss Waschbar Beidseitiger Digitaldruck Klare Farben Hochwertige Stoff, 45...
€19.99
inkl. MwSt. zzgl. Versand
Versand: €0.00

Bett Bettgestell Jugendzimmer Kollektion Kinderzimmer Modernes Holz Betten
€1,499.00
inkl. MwSt. zzgl. Versand
Versand: €0.00
PAYPER Fleecejacke NORWAY mit Innenkomfort, Reißverschluss und Taschen orange 3XL
€36.69
inkl. MwSt. zzgl. Versand
Versand: €5.00

DFV mobile - Fall Running Waist Pack Wasserdichte Gürteltasche Pouch zum Laufen Radfahren Motorrad Bike Sport für Tecno Pouvoir 1 - GRAU
€24.95
inkl. MwSt. zzgl. Versand
Versand: €0.00

MuchoWow Poster Frau - Blumen - Gold - Schwarz 30x20 cm - Plakate - Print
€15.99
inkl. MwSt. zzgl. Versand
Versand: €0.00

Briefe - Vincent Van Gogh (Buch)
€9.90
inkl. MwSt. zzgl. Versand
Versand: €0.00

für Simplon SILKCARBON, E-Bike Schnell-Ladegerät 36V 4A
€123.17
inkl. MwSt. zzgl. Versand
Versand: €3.95

MuchoWow Gerahmtes Poster Karte - Emden - Stadtplan 40x60 cm - Poster mit Schwarzem Bilderrahmen Wandposter Rahmen Foto Bilder - Poster in Rahmen
€42.99
inkl. MwSt. zzgl. Versand
Versand: €0.00

multifanshop Kapuzen Sweatshirt - Braunschweig - Meine Fankurve, schwarz-2, Größe M
€39.95
inkl. MwSt. zzgl. Versand
Versand: €3.95

ABAKUHAUS Kung Fu Wandteppich, Mann in Powerful Karate Pose aus Weiches Mikrofaser Stoff Waschbar ohne Verblassen Digitaldruck, 230 x 140 cm, Anthr...
€21.99
inkl. MwSt. zzgl. Versand
Versand: €0.00

Poster ️ Romantik mit Rotwein | Schmal | wandbild.com 80 x 200
€99.00
inkl. MwSt. zzgl. Versand

Jack & Jones Fusion Dots Print T-shirt Kinder
€7.95
inkl. MwSt. zzgl. Versand
Versand: €6.95

ABAKUHAUS Karikatur Wandteppich, Childish Bär Gesichter in Strickmützen Woods Pine Forest Wilderness, Wohnzimmer Schlafzimmer seidiges Satin Wand...
€46.99
inkl. MwSt. zzgl. Versand
Versand: €0.00

MuchoWow
€24.95
inkl. MwSt. zzgl. Versand
Versand: €0.00

Bio-Kollektion: 5er-Pack Baby Schlupfbodys braun Gr. 62 von vertbaudet
€29.99
inkl. MwSt. zzgl. Versand
Versand: €4.95

Abeba 4086 Sandale blau ESD - 44
€66.66
inkl. MwSt. zzgl. Versand
Versand: €0.00

Dressler Baukasten-Hose Sean aus Schurwolle, Shaped Fit in 50
€319.00
inkl. MwSt. zzgl. Versand

Interdeco Gardinenstange / Vorhangstange Silbergrau / Buche lackiert, Typ Adrian Holly (Kegel), 16 mm Ø 1-läufig, 400 cm
€60.30
inkl. MwSt. zzgl. Versand
Versand: €0.00
Pest Blut
€22.00
inkl. MwSt. zzgl. Versand
Versand: €0.99

Wechselmotiv ️ Golden Girl | Quadrat | wandbild.com
€69.00
inkl. MwSt. zzgl. Versand

Einmal Bullterrier - immer Bullterrier (hochwertiger Premium Wandkalender 2026 DIN A2 quer), Kunstdruck in Hochglanz
€74.99
inkl. MwSt. zzgl. Versand
Versand: €0.00

BLIC Außenspiegel Rechts 5402-04-9221921P
€82.50
inkl. MwSt. zzgl. Versand
Versand: €0.00

R7 Band Pegs
CHF 33.00
inkl. MwSt. zzgl. Versand

Schmuddelwedda Fleecejacke Frauen Fuchsie
€69.95
inkl. MwSt. zzgl. Versand
Versand: €0.00

Calvin Klein Obsession for Men Eau de Toilette Spray (75 ml)
€17.99(€239.87 / l)
inkl. MwSt. zzgl. Versand
Versand: €3.99

Handyhülle für Google Pixel 10 Leder Flip Klappbare Schutzhülle mit Standfunktion Braun
€11.99
inkl. MwSt. zzgl. Versand
Versand: €0.00

Küchenmatte 120x180 cm Vinylmatte Bodenmatte Dekoration - niedlich Cartoon Donuts
€109.99
inkl. MwSt. zzgl. Versand
Versand: €0.00

frost Untersetzer 1949
€97.58
inkl. MwSt. zzgl. Versand
Versand: €6.99

KIWISTAR Spinnrad - Spinnstuhl Stoff Spinnerei Wandtattoo in 6 Größen - Wandaufkleber Wall Sticker - Dekoration, Küche, Wohnzimmer, Schlafzimmer...
€24.99
inkl. MwSt. zzgl. Versand
Versand: €6.90

FHB Damen Bermuda Annika
€63.18
inkl. MwSt. zzgl. Versand
Versand: €6.99

Copenhagen Studios Pantolette Damen Größe 40 braun / schwarz
€139.00
inkl. MwSt. zzgl. Versand
Versand: €0.00

Edelstahl nahtlos Rohr DN25 Ø 33.4 x 6.35 mm in 100cm Länge | Werkstoff: 1.4307 V2A
€128.95
inkl. MwSt. zzgl. Versand
Versand: €8.99

Sada brzdovych desticek, kotoucova brzda
€15.52
inkl. MwSt. zzgl. Versand
Versand: €7.10

MAGNETI MARELLI Fensterheber 350103704000
€57.35
inkl. MwSt. zzgl. Versand

Poster mit Rahmen Silber "Tropen-Frosch" artboxONE - Tiere - Frog,Frosch,Animal,Tier,Tierportrait,Illustration,Buntstift
€54.99
inkl. MwSt. zzgl. Versand
Versand: €4.99

Basil 2Day Carry All KF Vorderradkorb (15 Liter | grau meliert)
€79.99
inkl. MwSt. zzgl. Versand
Versand: €4.99

Das Havelland und das Spreeland, Taschenbuch von Theodor Fontane, BoD - Books on Demand, 9783847823162
€24.80
inkl. MwSt. zzgl. Versand
Versand: €0.00

2-Zoll AHK-Einschub Adapter Erhöht US-AHK für Lincoln Aviator Bj. 2003-2005
€92.99
inkl. MwSt. zzgl. Versand
Versand: €0.00

Qoltec Docking station 2xHDD/SSD, USB 3.0
€40.76
inkl. MwSt. zzgl. Versand
Versand: €0.00

Ballin Est. 2013 Small Logo Shirt Grun - Große 3XL
€27.99
inkl. MwSt. zzgl. Versand
Versand: €2.95

DeinDesign Handyhülle für Xiaomi Poco F3 Silikon Hülle Case Smartphone Schutzhülle Star Wars Baby Yoda The Child
€28.95
inkl. MwSt. zzgl. Versand
Versand: €3.95

Schuhe Adidas Crazyflight 6 Mid KI8513
€180.00
inkl. MwSt. zzgl. Versand
Versand: €0.00

2x Original JOKIPIIN Saunakissen ''Mänty'' weiss/schwarz
€54.95
inkl. MwSt. zzgl. Versand
Versand: €0.00

Melissa Schuhe Campana Papel, ML3151252326, Größe: 40
€68.98
inkl. MwSt. zzgl. Versand
Versand: €0.00

Mexen Rox Badewanne Paravent 2-flügelig zum Schieben 100 x 150 cm, transparent, Chrom - 8C9-100-003-01-00
€4,179.99
inkl. MwSt. zzgl. Versand
Versand: €79.99

DFV mobile - Abdeckung Wasserdichtes Reflektierendes Armbandetui mit 2 Fächern Sport Laufen Fitness Radfahren für ZTE G Plus - Schwarz
€34.95
inkl. MwSt. zzgl. Versand
Versand: €3.95

Hans und Heinz Kirch
€2.30
inkl. MwSt. zzgl. Versand
Versand: €3.90

Aco Klara 05 Damenschuhe Sandalen Hoch Weiß Freizeit, Schuhgröße:38 EU
€53.50
inkl. MwSt. zzgl. Versand
Versand: €0.00

1 Stück für Luft- und Wassersilikon-Vakuumschlauch Hochtemperatur-Automobil-Vakuumschlauch 10Ft 5/8" 16mm ID 2,5mm Dicke Blau 130PSI Maximaldruck
€19.09
inkl. MwSt. zzgl. Versand
Versand: €0.00

24 Stück Regalträger Wandkonsole Regalbodenträger Regalwinkel Regalhalter, 19x11cm
€29.99
inkl. MwSt. zzgl. Versand
Versand: €4.99
SÖHNGEN Erste-Hilfe-Kasten Quick-CD 26 x 11 x 17 cm
€60.71
inkl. MwSt. zzgl. Versand
Versand: €9.17

Swinging Beginning
€25.99
inkl. MwSt. zzgl. Versand
Versand: €0.00

Georg Philipp Harsdörffers "Specimen Philologiae Germanicae"
€56.00
inkl. MwSt. zzgl. Versand
Versand: €0.99

Poster Talweg, groesse_poster:40x50 cm, groesse_rahmen:nur Poster
€14.99
inkl. MwSt. zzgl. Versand
Versand: €0.00

Herren Grafik T-Shirt London england urban seit 15 – London England Urban Since 15 – Geschenk 109 Geburtstag Jahrestag 109 Jahre Jubiläum 109 ...
€20.95
inkl. MwSt. zzgl. Versand
Versand: €4.95

artboxONE Puzzle "Map United Kingdom vintage craft" artboxONE - Reise,Kartografie
€39.99
inkl. MwSt. zzgl. Versand
Versand: €4.99

Gerlach.łyżka z otworami natur
€15.99
inkl. MwSt. zzgl. Versand
Versand: €0.00

Fränkische VMS-E 16 Steckmuffe Edelstahl (20850016), 16 mm, 5 Stck.
€154.41(€30,882.00 / ct)
inkl. MwSt. zzgl. Versand
Versand: €4.95

Poster ️ Goldene Flügel | Querformat | wandbild.com 80 x 60
€49.00
inkl. MwSt. zzgl. Versand

SPIDAN Faltenbalgsatz, Antriebswelle 25869
€26.33
inkl. MwSt. zzgl. Versand

Lurchi by Salamander Noah blau
€69.95
inkl. MwSt. zzgl. Versand
Versand: €2.95

iPhone 17 Schutzhülle mit MagSafe, stoßfest – Handyhülle Case Schutz
€24.99
inkl. MwSt. zzgl. Versand
Versand: €4.99

FEBEST 0510-049 Gelenksatz, Antriebswelle OE FG0525500A kompatibel mit 3
€48.00
inkl. MwSt. zzgl. Versand
Versand: €0.00

12x Menügabel TINA 18/0 Gabel, Besteck
€29.95
inkl. MwSt. zzgl. Versand
Versand: €8.95

Spannbild ️ Mops im Blütenmeer | Schmal | BigBilder 90 x 270 / Rahmen als Bausatz
€319.00
inkl. MwSt. zzgl. Versand

NRF Kühler, Motorkühlung 550347
€216.69
inkl. MwSt. zzgl. Versand
Versand: €0.00

DELPHI Bremsbelagsatz, Scheibenbremse LP3216
€30.09
inkl. MwSt. zzgl. Versand

Kiwistar - T-Shirt tailliert - Damen - Navy - Wandern Trekking Figur - mit Motiv Bedruckt - Funshirt Design - Sport - Freizeit - Damen - S
€14.99
inkl. MwSt. zzgl. Versand
Versand: €1.00

MuchoWow
€39.95
inkl. MwSt. zzgl. Versand
Versand: €0.00

Romantic Gothic Maxikleid
€115.95
inkl. MwSt. zzgl. Versand
Versand: €0.00

6x 9H Hartglas für Xiaomi Mi Note 10 FULL CURVED Displayschutz Panzerfolie Schutzfolie Panzerglas Schutzglas Displayglas Tempered Glasfolie Sicher...
€14.15
inkl. MwSt. zzgl. Versand
Versand: €0.00

Strap-it Polar Vantage M Nylon-Schnallenarmband (Schwarz/Grau)
€16.99
inkl. MwSt. zzgl. Versand
Versand: €0.00

The Divine Authority of Paul's Writings
€21.90
inkl. MwSt. zzgl. Versand
Versand: €0.99

Tassimo Bosch Kapselspender / Kapselhalter für Kaffeemaschine plus 1 Packung Tassimo Latte plus 1 Latte Glas plus Weihnachtschablonen 3er Set
€29.90
inkl. MwSt. zzgl. Versand
Versand: €0.00



